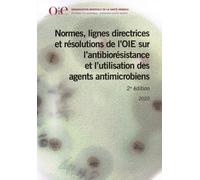
Normes, Lignes Directrices Et Résolution De L'oie Sur L'antibiorésistance Et L'utilisation Des Agents Antimicrobiens
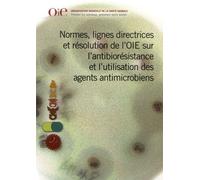
Normes, Lignes Directrices Et Résolution De L'oie Sur L'antibiorésistance Et L'utilisation Des Agents Antimicrobiens

![Cystiphane Ds Shampoing Anti-Pelliculaire Intensif Pellicules Intenses Et Persistantes Réduit Squames Et Rougeurs, Apaise Les Démangeaisons 2x200 Ml[Z2576]](https://cdn.prix.net/offer/fr/cystiphane-ds-shampoing-anti-pelliculaire-intensif-pellicules-intenses-et-persistantes-reduit-squame-200t1801895249a57f9d7aadff7cbf27a664fb1d8333e0e.jpg)
![Cystiphane S Shampoing Anti-Pelliculaire Pellicules Légères À Modérées Diminue Les Pellicules, Équilibre Et Apaise Lot De 2x200 Ml[Z3205]](https://cdn.prix.net/offer/fr/cystiphane-s-shampoing-anti-pelliculaire-pellicules-legeres-a-moderees-diminue-les-pellicules-equili-200t18002a69d0e52ff33b702e5d65554c32790a2d93c77.jpg)
🤖 Demande à ChatGPT
agents antimicrobiens et - Comparez les prix parmi 42 offres disponibles chez nos partenaires et achetez moins cher.
Grâce à prix.net, vous pourrez comparer les meilleures offres de nos partenaires pour le produit agents antimicrobiens et. Ce produit est présent principalement dans les catégories Livres & magazines, Soins cheveux et Accessoires pour baignoire. Vous pourrez comparer les prix parmi 42.
Quel est le meilleur prix pour agents antimicrobiens et ?
Au jour du 2025-12-29, la meilleure offre vous est proposée par amazon-marketplace.fr pour 9,90 €. Le prix est encore tropcher ? Attendez demain, mais attention, les prix peuvent augmenter.
Vous pourrez commander agents antimicrobiens et au meilleur prix chez amazon-marketplace.fr et bien d'autres.
Parmi nos 7 partenaires, amazon-marketplace.fr, Amazon.fr et Rakuten.com FR vous offriront les meilleurs prix de nos marchands partenaires. Prix.net c'est l'accès à des centaines de commercants présent sur la toile.
Liste des marchands proposant la recherche agents antimicrobiens et:
- amazon-marketplace.fr
- Amazon.fr
- Rakuten.com FR
- parfumdreams.fr
- getgoods.com (FR)
- Fnac.com
- deporvillage.fr
agents antimicrobiens et amazon-marketplace.fr
Trouvez agents antimicrobiens et sur amazon-marketplace.fr. Connaissez-vous déja notre partenaire ? Ceux-ci sont scrupuleusement choisi par nos équipes par la qualité de leur service.
agents antimicrobiens et est en vente en ligne et est proposé par plusieurs marques sur internet.
Nos partenaires vous proposent agents antimicrobiens et des marques Duck, L&L ainsi que Charlotte Meentzen.
Il n'y a pas de recherche similaire à cet requête. Choississez un autre produit le moteur de recherche de produit de prix.net si vous êtes intéressé par un produit ressemblant ou s'y raprochant.
Il existe 4 couleurs pour ce produit et la couleur la plus recherchée est
agents antimicrobiens et vous est proposé en 4 couleurs. Les coloris les plus appréciés sont Marron, Gris et Blanc. Adaptez la couleur idéale pour votre recherche.
- Marron
- Gris
- Blanc
- Noires
Comparer les prix avant tous achats en ligne
Grâce aux comparateurs de prix, vous pouvez bénéficier des meilleurs prix pour vos achats en ligne. Il vous suffit de rechercher un produit spécifique et nous vous montrerons toutes les offres de nos partenaires. Vous pourrez ainsi trouver le prix qui vous convient pour votre commande. Vous aurez également la possibilité de choisir vos modes de règlement favoris. Les délais de livraison de chaque marchand en ligne sont également indiqués.
Comment fonctionne notre comparateur de prix ?
Un comparateur de prix permet d’analyser en un instant les meilleurs prix et meilleures offres chez des centaines de marchands partenaires. Lorsque vous entrez une recherche de produit, nous vous présenterons un clin d’œil toutes les offres partenaires parmi les plus grands acteurs du web. Inutile de perdre de longues heures en ligne à naviguer entre plusieurs commerçants. Vous aurez accès aux offres proposées par ces centaines de marchand sur prix.net et souvent au meilleur prix. Les offres des marchands sont actualisées plusieurs fois par jour pour vous proposer les prix en temps en réel.